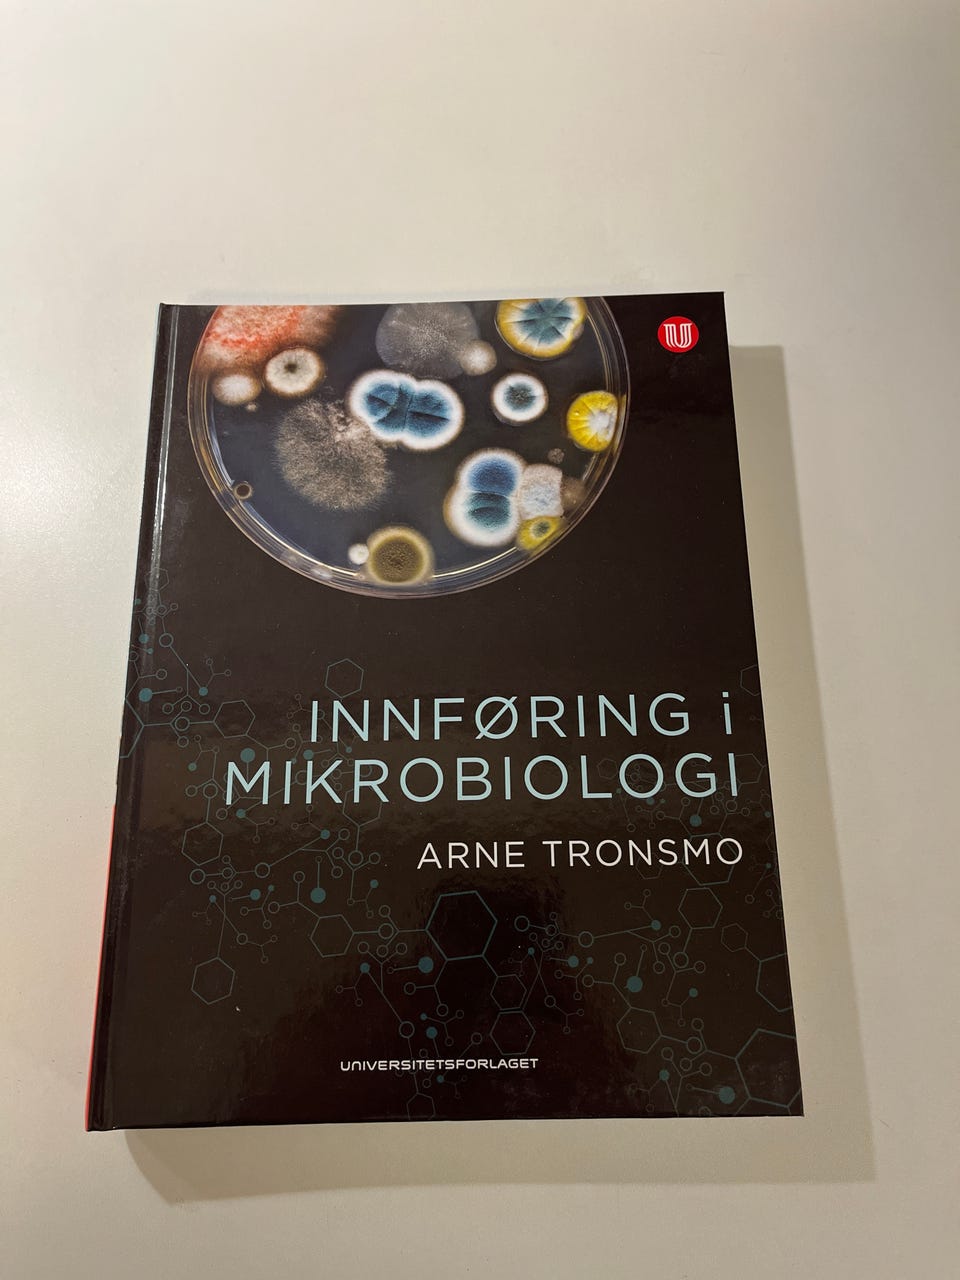
Galleribilde

Bildegalleri
Pensumbøker til Biomarin Innovasjon
Til salgs
350 kr
Beskrivelse av varen
Tilstand: Pent brukt - I god stand
Selger mine bøker som er brukt til studiet Biomarin innovasjon. Ingen av bøkene er skrevet eller tegnet i. Alle bøkene er i pen stand med et par unntak.
Ved kjøp av flere bøker gis pakkepris.
Kan sendes.
Bøker:
Sinus matematikk - 350kr
Økonomi styring - 250kr
Matematikk for økonomistudenter - 300kr
Årsregnskapet Lærebok - 250kr
Marine Biology (Mc Graw Hill) - 300kr
Fra idé til virksomhet - 250kr
Himmelsk kjemi - 350kr
Tabeller og formelsamlinger - 100kr
Innføring i mikrobiologi - 300kr
Ethics and science - 100kr
Psykologi i organisasjon og ledelse - 300kr
LMR Målrettet personal og kompetanseledelse - 150kr
Årsregnskapet Oppgavesamling - 50kr(vannskadet siste 100 s., men brukelig.)
Markedsføringsledelse - 50kr (vannskadet siste 200 s., men brukelig)
SOLGT:
Elektroteknikk 400kr
Entreprenørskap og innovasjonsledelse 200kr
Product design and development 300kr
Business Model Generation 200kr
Marine Ecology (Oxford)300kr
Marine Biology (Mc Graw Hill) 300kr
Akvakultur 400kr
Videreforedling av fisk 450kr
Brukerprofil
Du må være logget inn for å se brukerprofiler og sende meldinger.
Logg innAnnonsens metadata
Sist endret: 14.1.2026 kl. 22:41 ・ FINN-kode: 385920531